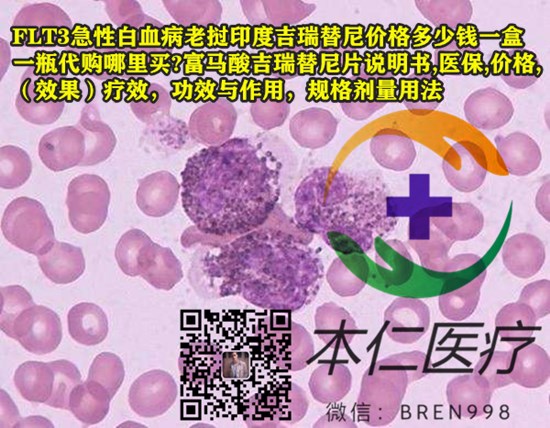

吉瑞替尼主要用于治疗携带FLT3突变的复发性或难治性急性髓系白血病(AML)的成人患者。它是一种FLT3抑制剂,能够对大约1/3急性髓系白血病患者中发现的两种常见FLT3突变产生抑制作用。
维奈克拉与吉瑞替尼的区别是什么?
维奈克拉和吉瑞替尼在适应症、副作用以及药物机制等方面都存在显著的区别。维奈克拉主要用于治疗慢性淋巴细胞白血病(CLL)、小淋巴细胞淋巴瘤(SLL)和其他血液肿瘤。它通过靶向并抑制Bcl-2蛋白,促使癌细胞走向程序性死亡。此外,维奈克拉也可以与阿扎胞苷联合使用,治疗因合并症不适合接受强诱导化疗,或者龄75岁及以上的新诊断的成人急性髓性白血病患者。
吉瑞替尼和维耐克拉哪个好?
针对,治疗携带FLT3突变的患者,吉瑞替尼更好。吉瑞替尼主要用于治疗携带FLT3突变的复发性或难治性急性髓系白血病(AML)的成人患者。它通过抑制FLT3受体信号转导和增殖来发挥抗肿瘤作用,对FLT3突变具有高选择性,能够同时抑制常见的FLT3突变。吉瑞替尼的常见副作用包括消化系统问题、疲劳、头痛等。
印度吉瑞替尼一盒售价在4200元至4350元之间,一瓶为一个月份的用量,含有40mg的药物,共计90片。可以通过本仁海外医疗【微信bren998】进行购买。